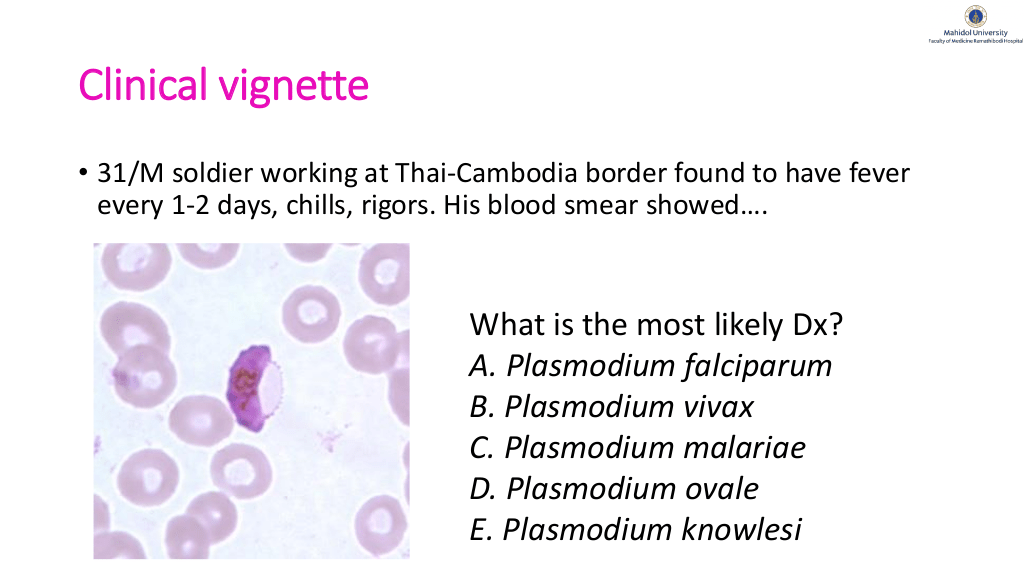
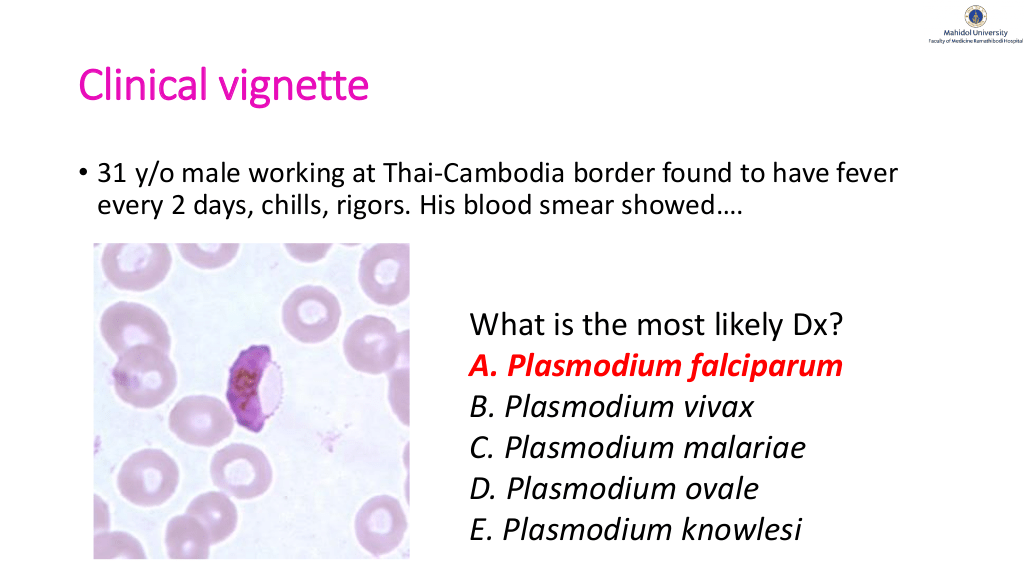
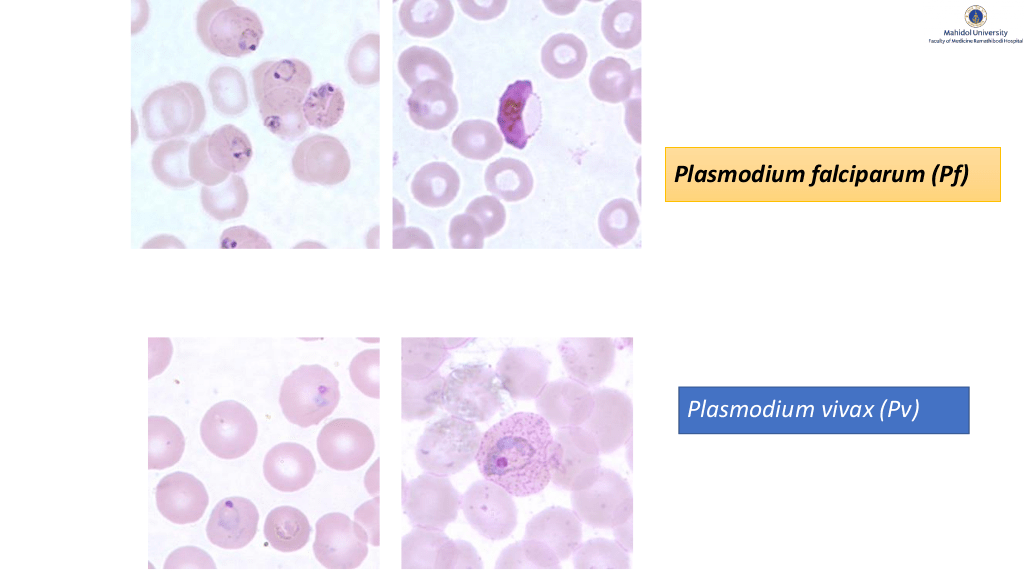
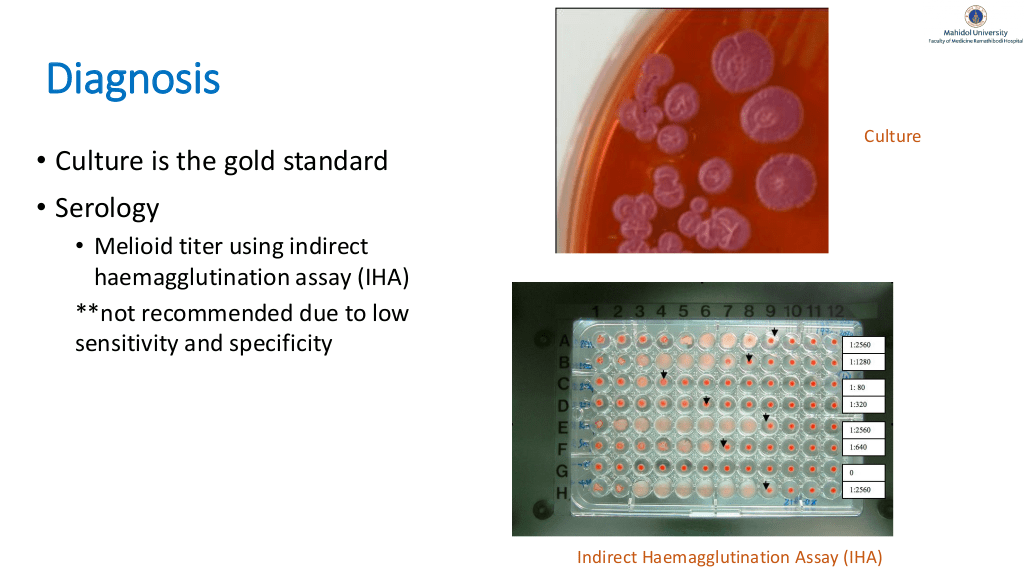

1/93
関連するスライド
AWaReな抗菌薬の話
水谷肇
2801
49
「Q&A付き」 " やってみよう!戦略的抗菌薬選択 "
山口裕崇
62702
168
入院患者の発熱の語呂合わせ
関川喜之
19179
147
初期研修医向けグラム陰性桿菌の基本
関川喜之
2958
24
Tropical infectious diseases found in Southeast and South Asia
1,989
4
概要
Tropical infectious diseases found in Southeast and South Asia
本スライドの対象者
専攻医/専門医
投稿された先生へ質問や勉強になったポイントをコメントしてみましょう!
0 件のコメント
MaudeRapeephanさんの他の投稿スライド
このスライドと同じ診療科のスライド
テキスト全文
トロピカルメディスンと感染症の概要
#1.
Tropical Medicine and Global Health Lecture series: Tropical infectious diseases found in Southeast and South Asia Rapeephan R. Maude, MD, MSc, DTM&H Division of Infectious Diseases, Department of Medicine, Faculty of Medicine, Ramathibodi Hospital Mahidol University
#2.
Disclosure • Honorarium speaker for • Pfizer • Janssen (Johnson and Johnson) • Gilead
トロピカルメディスンの父とその影響
#3.
Sir Patrick Manson (1844-1922) Father of Tropical Medicine
デング熱の症状と診断方法
#5.
Clinical Vignette 50 y/o American female visiting Bangkok, Thailand in August 2022 (rainy season) presented to your clinic with high fever, periorbital headache, generalized muscle pain for 2 days. Labs showed hemoconcentration, thrombocytopenia and leukopenia with lymphocyte predominated. What is the most likely diagnosis? A. Malaria B. Dengue C. Scrub typhus D. Chikungunya E. Leptospirosis
#6.
Dengue • Arboviral infection • Dengue virus (DENV) belonging to the Flaviviridae family • Found in tropical and sub-tropical climates worldwide, mostly in urban and semi-urban areas. • DENV serotypes – DENV1-4 – co-circulate around the tropical disease and cause human infection. • It is possible to infect 4 times https://www.who.int/news-room/fact-sheets/detail/dengue-and-severe-dengue. Accessed on 8th December 2022 Zeyaullah M, et al. Vaccines. 2022
#7.
Transmitted by female mosquitoes mainly of the species Aedes aegypti and Ae. albopictus.
#8.
Questions • Are Aedes aegypti and Ae. Albopictus the vectors of other disease?
#9.
Aedes aegypti and Ae. Albopictus •Dengue •Chikungunya •Yellow fever •Zika virus https://en.wikipedia.org/wiki/Aedes_aegypti. Accessed on 8th December 2022
#10.
Zeyaullah M, et al. Vaccines. 2022
重症デング熱の管理と予防策
#12.
WHO classification 1997 Dengue fever Dengue hemorrhagic fever Dengue shock syndrome 2009 Dengue without warning signs Dengue with warning signs Severe dengue
#13.
Severe dengue • Life-threatening spectrum • Leading causes of serious illness and death in some Asian and Latin American countries • Rapid diagnosis and proper management are crucial. • Early detection of disease progression associated with severe dengue and access to medical care lowers fatality rates to below 1% in WHO report in 2022. https://www.who.int/news-room/fact-sheets/detail/dengue-and-severe-dengue. Accessed on 8th December 2022
#14.
• • • • Children Secondary infection Diabetes Renal diseases
#15.
Diagnosis
#16.
Zeyaullah M, et al. Vaccines. 2022
#17.
Modified from WHO guideline
#18.
Zeyaullah M, et al. Vaccines. 2022
#19.
Dengue prevention https://www.cdc.gov/dengue/vaccine/hcp/index.html. Accessed on 8th December 2022 https://www.reuters.com/business/healthcare-pharmaceuticals/urgent-takedas-dengue-vaccine-wins-eu-approval-2022-12-08/ Accessed on 8th December 2022
マラリアの臨床症例と診断
#20.
Dengvaxia • a tetravalent, live-attenuated dengue vaccine. • using recombinant DNA technology and replaces several genetic sequences in a yellow fever vaccine virus genome with the homologous sequences from the four dengue virus serotypes. https://www.cdc.gov/dengue/vaccine/hcp/index.html. Accessed on 8th December 2022 https://www.mims.com/thailand/drug/info/dengvaxia?type=full. Accessed on 8th December 2022
#21.
https://www.cdc.gov/dengue/vaccine/hcp/index.html. Accessed on 8th December 2022
#22.
Pre-vaccination Checklist https://www.cdc.gov/dengue/vaccine/hcp/eligibility/checklist.html. Accessed on 8th December 2022
#23.
Clinical vignette • 31/M soldier working at Thai-Cambodia border found to have fever every 1-2 days, chills, rigors. His blood smear showed…. What is the most likely Dx? A. Plasmodium falciparum B. Plasmodium vivax C. Plasmodium malariae D. Plasmodium ovale E. Plasmodium knowlesi
#24.
Clinical vignette • 31 y/o male working at Thai-Cambodia border found to have fever every 2 days, chills, rigors. His blood smear showed…. What is the most likely Dx? A. Plasmodium falciparum B. Plasmodium vivax C. Plasmodium malariae D. Plasmodium ovale E. Plasmodium knowlesi
マラリアの種類と特徴
#25.
Malaria • Most devastating tropical infectious disease • Approximately 229 million infections per year • Over 400,000 deaths per year worldwide • Worse situation after COVID-19 pandemic https://www.drugtargetreview.com/news/54877/new-capillary-model-could-provide-new-therapies-for-malaria/ Accessed on 13th February 2022 WHO Guidelines for malaria. WHO Guidelines Approved by the Guidelines Review Committee. Geneva, 2021
#26.
Sir Ronald Ross (1857-1932) Ross made his landmark discovery and proved the role of Anopheles mosquitoes in the transmission of malaria parasites in human. www.nobelprize.org
#27.
CDC Health Information for International Travel 2020.
#28.
Malaria in Thailand: • P. vivax approximately 80% and P. falciparum <20% • P. knowlesi, P. malariae and P. ovale rare https://www.cdc.gov/parasites/malaria/index.html Accessed on 13thFebruary 2022
#29.
Brazil P, et al. Lancet Glob Health 2017.
#30.
6 human malaria species Plasmodium falciparum (Pf) Plasmodium vivax (Pv) Plasmodium ovale (Po) Plasmodium malariae (Pm) Plasmodium knowlesi (Pk) Plasmodium simium (Ps)
マラリアの重症化と診断基準
#31.
Key characteristics for each Plasmodium spp. Species Characteristics Plasmodium falciparum (Pf) invades RBCs of all ages and thus can causes the most severe disease via microvascular and organ-damage. Plasmodium vivax (Pv) invades reticulocytes and can cause severe diseases; can persist in hepatocytes as hypnozoites for months to years. Plasmodium ovale (Po) can also persist in hepatocytes for months to year. Plasmodium ovale curtisi (P. o. curtisi) and Plasmodium ovale wallikeri (P. o. wallikeri). Plasmodium malariae (Pm) causes low level parasitemia and is typically a mild disease. Plasmodium knowlesi (Pk) morphologically resembles PM but causes severe diseases like PF or PV. Niche area in SEA esp. Malaysia, Thailand Plasmodium simium (Ps) morphologically resembles PV. Niche area in Brazil.
#32.
1000 cases vs 1000 controls Maude RJ, et al. Malaria journal. 2021.
#33.
https://apps.who.int/malaria/maps Accessed on 1st February 2022
#34.
Malaria life cycle https://www.cdc.gov/parasites/malaria/index.html Accessed on 1st February 2022
#35.
Types of infection and clinical manifestation Primary attack Relapse Recrudescence Reinfection • • • • • Fever Chills Malaise Fatigue Diaphoresis • • • • • Headache Cough Nausea/vomiting abdominal pain Diarrhea
#37.
Complicated/severe malaria • Impaired consciousness • Respiratory distress Pulmonary edema • Significant bleeding • Shock Clinical • Hypoglycemia • Severe anemia • Renal impairment • Metabolic acidosis • Jaundice • Hyperparasitemia Laboratory
マラリアの診断技術と治療法
#39.
Maude RJ, et al. Malaria journal. 2014.
#40.
Diagnosis Thick and Thin film on light microscopy
#41.
Plasmodium falciparum (Pf) Plasmodium vivax (Pv)
#43.
Rapid Diagnostic tests (RDTs) Immuno-chromatographic tests • PfHRP2-based RDTs: unable to distinguish new infections from recently and effectively treated infections, due to the persistence of PfHRP2 in the blood for 1–5 weeks after effective treatment • Not suitable for Amazon region due to variable frequencies of HRP2 deletions in P. falciparum parasites • poor sensitivity for detecting P. malariae and P. ovale; • the heterogeneous quality
#44.
Immunodiagnosis and NAAT • Immunodiagnosis • Nucleic acid amplification test(NAAT) methods • PCR • Loop-mediated isothermal amplification Useful for studies of drug resistance and other specialized epidemiological investigations
メリオイドーシスの病因と臨床症状
#46.
Jacob CG, et al. Elife. 2021
#47.
Spatial distribution of K13 markers in Asia Kagoro FM, et al. Lancet Microbe 2022
#49.
Treatment Artemisinin derivatives Quinoline Antifolate Antimicrobials Investigational drugs Figure from https://www.uptodate.com Accessed on 1st March 2021
#50.
Treatment of complicated/severe malaria IV Artesunate ACT (3d) IV Quinine ACT (3d) OR Quinine + doxycycline/clindamycin (7d) OR Artesunate + doxycycline/clindamycin (7d) ACT: Artemisinin-Combination Therapy = One of the artemisinin drug class with a partner drug
#51.
https://www.cdc.gov/malaria/travelers/country_table/t.html Accessed on 29th July 2020
#52.
Vaccines against malaria RTS,S/AS01 R: Repeat region of circumsporozoite protein of Pf T: T-cell epitopes of CSP S: Hepatitis B Surface Antigen; HBsAg S: Free ‘S’ Protein AS: adjuvant system https://www.cdc.gov/parasites/malaria/index.html Accessed on 1st March 2022
#53.
Case AZ • 65 y/o female, farmer from Bangladesh, presented with tenderness at right axilla for 2 days. • She developed a small wound at her right 2nd finger while in the rice farm 12 days prior to visit. • Incision and drainage showed yellowish pus as in the future.
#54.
Pus culture showed numerous WBC and safety-pin gram negative bacilli.
#55.
MALDI-TOF
#56.
Melioidosis • Burkholderia pseudomallei • A small, motile, Gram-negative , non-fermentative bacillus • Environmental saprophyte found in soil and water in the tropics. • Acquired through inoculation or inhalation from soil or water containing the organisms
サルモネラ感染症とその治療法
#57.
Limmathurotsakul D, et al. Nature Microbiology 2016
#58.
The Centers for Disease Control and Prevention (CDC) identified Burkholderia pseudomallei for the first time in the environment in the continental United States. https://www.emergency.cdc.gov/han/2022/pdf/CDC_HAN_470.pdf. Accessed on 8th December 2022
#59.
Clinical manifestations • • • • Incubation period 1-21 days (median 9 days). Most infection are probably asymptomatic Acute disease is defined as symptoms lasting for less than 2 months before diagnosis. Latent infection with reactivation - as long as 26-62 years in the US following Vietnam war. Pneumonia Skin ulcers Abscesses (liver, spleen, parotid gland) Genitourinary Septic arthritis and osteomyelitis Encephalomyelitis Bacteremia and septic shock
#60.
Currie BJ, et al. PLoS NTD 2010
#61.
Diagnosis • Culture is the gold standard Culture • Serology • Melioid titer using indirect haemagglutination assay (IHA) **not recommended due to low sensitivity and specificity Indirect Haemagglutination Assay (IHA)
#62.
TMP-SMX is not inferior to TMP-SMX plus doxycycline for the oral phase of melioidosis treatment, and is preferable on the basis of safety and tolerance by patients. Chetchotisakd P, et al. Lancet 2013
#63.
Treatment IV ceftazidime OR meropenem for 10-14 days PO trimethoprim-sulfamethoxazole OR amoxicillin/clavulanic acid for 3-6 months
#64.
Thank you Rapeephan R. Maude, MD, MSc, DTM&H Contact: Rapeephan.maude@gmail.com
#65.
Enteric fever • Foodborne illness, often in an outbreak setting • severe systemic illness with fever and abdominal pain. • Classic organisms: Salmonella enterica serotype Typhi and Salmonella enterica serotype Paratyphi A, B, C • Nontyphoidal Salmonellae: S. enteritidis and S. typhimurium. • Severe cases associated with HIV infection. • Incubation period: 5-12 days • Human are the only reservoir for S. Typhi. • Chronic carriage: excretion of organism in stool or urine > 12 months after acute infection. www.microbwiki.com
#66.
Classic clinical presentation Fever with chills. Relative bradycardia. Pulse-temperature dissociation. Abdominal pain and rose spots Intestinal bleeding or perforation, hepatosplenomegaly, secondary bacteremia, peritonitis and septic shock. Rose spots: faint salmon-colored macules on trunk and abdomen Parry CM, et al. NEJM 2002
#67.
Treatment for Salmonella spp. Treatment is not recommended for mild-to-moderate gastroenteritis in immunocompetent patients ->>> self-limiting • Treatment is for • Severe illnesses • High risk group e.g. extreme age-- young children, elderly • Immunocompromised • Primary regimen – ciprofloxacin OR ceftriaxone 7-14 days • Alternative regimen – cefixime, azithromycin, chloramphenicol, Bactrim • Severe typhoid fever (caused by S. typhi) -> consider concomitant dexamethasone
#68.
Other aspects of Salmonella infection • Perforation of Peyer’s patch -> complications in the 3rd week of illnesses • Chronic carrier found commonly in patients with cholelithiasis -> 1-6% • Relapse 1-6% if treated with first-line regimen and 10-20% with second-line regimen
チクングニア熱の診断と治療
#69.
Parry CM, et al. ACC 2015
#70.
Typhoid fever patients had lower microbiota richness and alpha diversity and a higher prevalence of potentially pathogenic bacterial taxa. Haak BW, et al. OFID 2020
#71.
Clinical Vignette 31 y/o female from Florida visiting Chiang Mai, northern Thailand, presented with high fever, rash and multiple joint pain for 5 days. Many people in the same tour got similar symptoms. What is the most likely diagnosis? A. B. C. D. E. Malaria Dengue Scrub typhus Chikungunya Zika
#72.
Chikungunya • An arthropod-borne alphavirus • Transmitted by mosquito • Clinical manifestation • • • • Acute febrile polyarthralgia Inflammatory arthritis Cutaneous eruption Fever
#73.
Chikungunya: diagnosis and treatment Diagnosis Chikungunya viral RNA via RT-PCR Chikungunya viral serology Viral culture – research tool Treatment Supportive treatment NSAIDS Pain control Prevent disability from arthritis
#74.
DDx Dengue thrombocytopenia, shock Chikungunya joint pains, milder illness than dengue Yellow fever transaminitis, jaundice, no vaccine prior to travel to endemic area Leptospirosis conjunctival suffusion, hyperbilirubinemia out of proportion to transaminitis
#75.
Scrub typhus • Orientia tsutsugamushi (previously called Rickettsia tsutsugamushi) • Obligate intracellular coccobacilli • There are three variants or strains – Karp, Gilliam and Kato. • Infection with one strain does not preclude reinfection with a different strain. • Transmitted to humans through the bite of the larval stage of infected chigger mites. www.sciencephoto.com
#76.
Scrub typhus • Incubation period : 7-10 days after the bite of chigger mites • A major cause of acute febrile illness in the Asia-Pacific region with some reports in South America and Africa. Risk factors • Farmers • Young children and 40-60 years old • Summer and Autumn
ハンセン病の病因と臨床的特徴
#78.
Clinical manifestations • Fever • Eschar • Rash • Generalized intense headache • Diffuse myalgia • Relative bradycardia • Malaise • Regional lymphadenopathy • Nausea, vomiting and diarrhea • Cough Severe: multiorgan failure and death Taniguchi, Y.Dermatology Online Journal
#79.
Diagnosis • Indirect immunofluorescence assay (IFA) – gold standard but need expertise and infrastructure • A four-fold rise in titers over a 14-day period is conclusive • ELISA – new gold standard. More convenient and higher sensitivity • PCR – technically difficult • In vitro isolation of O. tsutsugamushi – need a biosafety level 3 facility
#80.
Scrub typhus: treatment • Doxycycline – drug of choice • Chloramphenicol – high potency but more toxicity particularly bone marrow suppression • Azithromycin in pregnant women
#81.
Leprosy (Hansen’s disease) • Caused by Mycobacterium leprae and Mycobacterium lepromatosis • Obligated intracellular parasites • Acid-fast organism • Involves the skin and peripheral nerves • Early diagnosis is important to decrease the risk for permanent disability. https://www.uptodate.com. Accessed on 23rd September 2022
#82.
Leprosy • The top five countries reporting new cases are India, Brazil, Indonesia, Nepal, and Bangladesh • Risk factors Close contact with patients With leprosy Amadillo exposure Immunosuppression such as HIV, organ transplant The nine-banded armadillo (Dasypus novemcinctus) https://www.wildtexas.com/nine-banded-armadillo-dasypus-novemcinctus/ accessed on 23rd September 2022
#83.
Leprosy ●Tuberculoid (TT) ●Borderline tuberculoid (BT) ●Mid-borderline (BB) ●Borderline lepromatous (BL) ●Lepromatous (LL) ●Indeterminate (I)
#84.
Leprosy ●Hypopigmented or reddish patch(es) on the skin ●Diminished sensation or loss of sensation within skin patch(es) ●Paresthesias (tingling or numbness in the hands or feet) ●Painless wounds or burns on the hands or feet ●Lumps or swelling on the earlobes or face ●Tender, enlarged peripheral nerves https://www.uptodate.com. Accessed on 23rd September 2022
狂犬病の予防と治療法
#85.
Strayed animals are commonly found in Southeast and south Asia https://www.cdc.gov/rabies/about.html Accessed on 23rd September 2022
#86.
Rabies • Causes by the Rabies virus • different variants and species of neurotropic viruses in the Rhabdoviridae family, genus Lyssavirus. • HIGHEST CASE FATALITY rate of any human infectious disease. https://www.cdc.gov/rabies/about.html Accessed on 23rd September 2022
#87.
Rabies • Incubation period – several days to years • Transmission • saliva of rabid animals (90%) • tissue/organ transplantation. https://www.animalmedical.net/blog/2021/09/what-happens-when-your-dog-bites-someone-and-what-steps-to-take/. Accessed on 23rd September 2022
#88.
Rabies – clinical manifestations Prodromal symptoms Clinical rabies Final state • Non-specific symptoms such as fever, weakness, anorexia, N/V, headache. • 2-7 days • Encephalitic (furious) 80% - Fever, hydrophobia, pharyngeal spasms, hyperactivity, coma and death • Paralytic (dumb) – mimic Guillain-Barre syndrome • Most patients with rabies die within 2 weeks after coma. • A few cases of survivors found to have a severe neurological damage
#89.
Tetanus immunization in animal bites • early and vigorous cleansing with soap and water • use of an antiseptic with activity against rabies virus • povidone iodine • 2% benzalkonium chloride • Animal bites are at risk for tetanus
#90.
Wound management and tetanus prophylaxis Previous dose of tetanus toxoid < 3 doses or unknown ≥ 3 doses Clean and minor wound Vaccine* Immunoglobulin** contaminated or large wound Vaccine* Immunoglobulin** ✓ ✓ ✓ If last dose given ≥10 years ago If last dose given ≥5 years ago *Vaccine – tetanus toxoid containing vaccine such as DT, DtaP, Td, Tdap or TT **Immunoglobulin – human tetanus immune globulin Persons with HIV infection or severe immunodeficiency who have contaminated wounds should receive human tetanus immune globulin, regardless of their history of tetanus immunization. 1.Havers FP, et al. MMWR Morb Mortal Wkly Rep 2020; 2. Liang JL, et al. MMWR Recomm Rep 2018
#91.
Postexposure rabies prophylaxis Postexposure prophylaxis (PEP) should be administered to all patients who have had a known or likely exposure to rabies even if they got prior preexposure prophylaxis (PrEP)
#92.